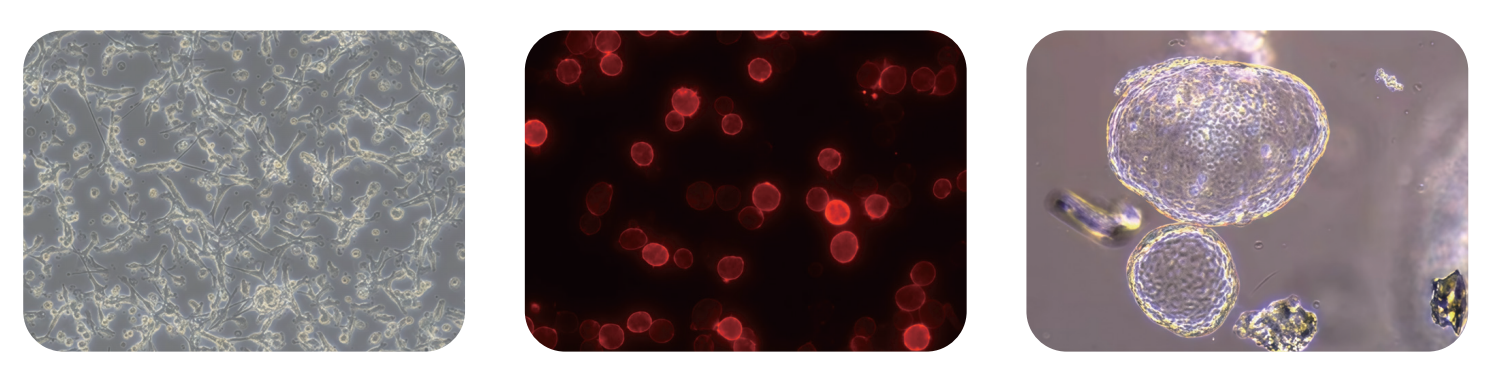

-

联系电话
热线电话
+86-15221725700
-

添加微信
微信扫一扫添加

-

回到顶部
联系我们

活细胞扫描分析仪
产品描述
可放置在培养箱对活细胞进行长时间观察,监测以及分析;可匹配不同类型以及不同规格的多孔板、培养瓶以及培养皿等;高精度XYZ三轴电动控制,可实现指定区域扫描和全视野扫描配置明场相差和三荧光通道,双物镜设计,满足各类细胞实验要求;软件具有拍照、录像、延时摄影、细胞计数、细胞汇合度、划痕实验细胞活性分析等功能,可扩展A1分析功能。
拍摄图
技术参数
| 型号 | TOW-MCS-PRO |
| 明场观察 | 透明相差照明,工作距离55mm |
| 长寿命低光毒性LED光源:625nm | |
| 荧光观察 | 蓝色(B):472-495nm |
| 绿色(G):543-560nm | |
| 紫外(UV):393-416nm | |
| 物镜 | 电动物镜切换,标配10X/20X,4X物镜可选 |
| 载物台 | 电动XY移动平台 行程115*75mm |
| Z轴 | 电动对焦机构,可自动对焦 |
| 相机 | 高速高灵敏度相机5000W 2/3英寸 40fps |
| 软件 | 支持远程控制,包含灯光控制、相机控制、拍照、录像、延时摄影 |
| 分析功能 | 细胞计数、细胞汇合度、划痕实验、转染效率、活性分析;外网控制、邮件提醒 |
| 扫描功能 | 多孔扫描:自定义设置XY阵列多点拍照,明场、荧光多通道叠加 |
| 区域扫描:设置矩形区域全景扫描拼接,明场、荧光多通道叠加 | |
| 数据传输/供电 | USB数据线+DC供电线 |
| 工作环境 | 5-40℃,20-95%RH |
| 尺寸 | 377mm*252mm*208mm |
应用领域




此介绍及参数为产品基础信息,可能滞后于产品更新,具体参数请与我司联系。